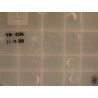
COMPTEUR

Porte avant gauche occasion OPEL MERIVA II Phase 1 09-2010->03-2014 1.7 CDTI 110ch 39144651
Commande de chauffage occasion OPEL MERIVA II Phase 1 09-2010->03-2014 1.7 CDTI 110ch 13346091
Feu arrière gauche occasion OPEL MERIVA II Phase 1 09-2010->03-2014 1.7 CDTI 110ch 13307493
Commande essuie glace occasion OPEL MERIVA II Phase 1 09-2010->03-2014 1.7 CDTI 110ch 20964885
Commande clignotant occasion OPEL MERIVA II Phase 1 09-2010->03-2014 1.7 CDTI 110ch 13294825
Debimetre air occasion OPEL MERIVA II Phase 1 09-2010->03-2014 1.7 CDTI 110ch 12671610
Transmission avant gauche occasion OPEL MERIVA II Phase 1 09-2010->03-2014 1.7 CDTI 110ch 13248645
Moyeu avg occasion OPEL MERIVA II Phase 1 09-2010->03-2014 1.7 CDTI 110ch 12779002
Moyeu avd occasion OPEL MERIVA II Phase 1 09-2010->03-2014 1.7 CDTI 110ch 12779002
Antivol de direction occasion OPEL MERIVA II Phase 1 09-2010->03-2014 1.7 CDTI 110ch 23276089